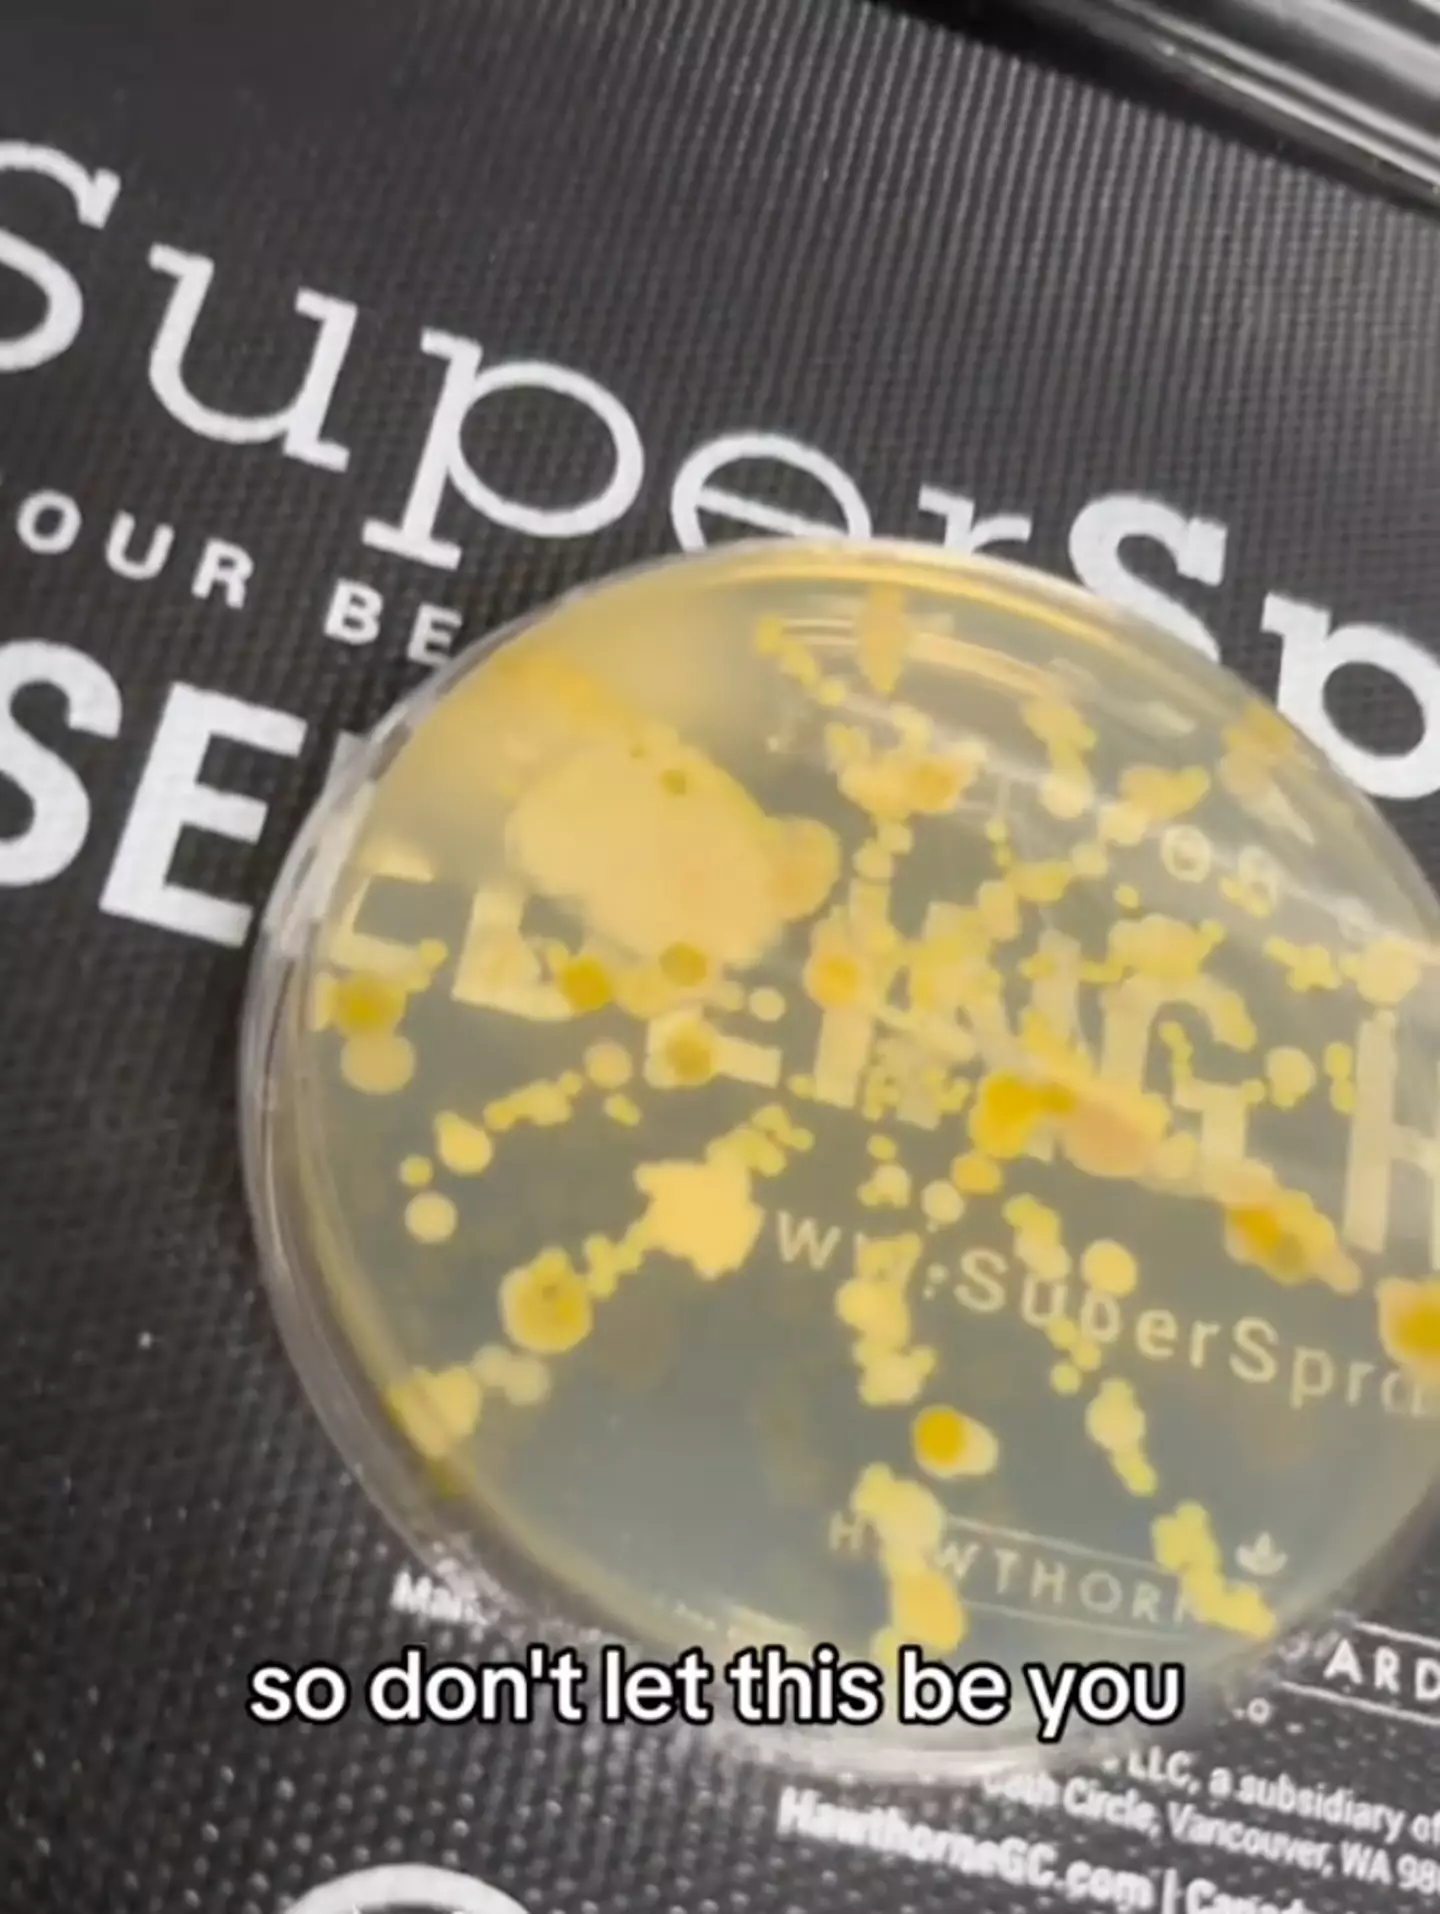
TikTok/@manifested_this

This article contains affiliate links and LADbible Group might make a commission on anything purchased.
Today, people made a shocking discovery about loofahs, and haven’t been able to look at their shower in the same way since.
According to leading dermatologist Joel Schlessinger MD, you should avoid using the popular sponge, as bacteria can ‘multiply within its nooks and crannies’. It’s that dirty, he wouldn’t even touch one himself.

Advert
On TikTok, word has got out, and one social media user has tested loofahs to see what would happen. Using loofahs that are ‘only a few days old’, he takes a swab from each - and the results are horrifying.
In the clip, he shows followers how much bacteria has grown in the petri dish, and we can guarantee you’ll throw your loofah out after watching it.
Thankfully, he has offered a solution that won’t cost your health - or break the bank.
Advert
Advert
With hundreds of rave reviews online, the Sud Scrub is a ‘great alternative’ to a loofah, and people say it has ‘transformed’ their skin in the process, from reducing acne to calming eczema.
One happy customer wrote, “In just three weeks, my chest and back acne has disappeared and all I’ve done is change my scrubber!”
Another five-star review reads: “The best decision I have made is buying the Sud Scrub. I was a die hard loofah person. I hated how loofahs would fall apart, did not wash well, and were dirty. The Sud Scrub is three times more sudsy, it rinses out so much easier, and is easy to clean. I feel cleaner and it holds up better.”
Advert
A third simply shared: “Very grateful to have found this product. In just two weeks, it has helped my eczema so much.”
How does it work?
The Sud Scrub is made from non-toxic food-grade silicone that is designed to last for up to one year. Built with antimicrobial silver and zinc, the website states it will ‘resist 99.9% of odour-causing bacteria and mould’.
The wonder product is on hand to ‘exfoliate and massage’ sensitive skin and can be hung up in the shower when not in use.
Advert

People have credited the product with reducing acne, helping to calm eczema, and for giving them ‘softer skin’. Customers have also said the product ‘is worth the money’ and has ‘lasted them ages’ - sure beats buying a new loofah every week.
Where to buy the Sud Scrub in the UK
Although a US product, you'll be pleased to know the Sud Scrub can be purchased in the UK and will ship here too. It's selling for $29.99 (roughly £23) on the official website but make sure to hurry, it's sure to fly from the shelves.